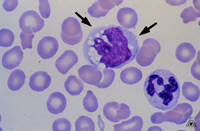
фото 4

Основные функции
Моноциты являются самыми крупными и активными клетками в составе лейкоцитарной формулы. Они образуются в костном мозге и с током крови распределяются по всем частям организма. Их жизненный цикл короток, однако новые молодые клетки постоянно вырабатываются для замены зрелых.
Значение моноцитов для здоровья организма трудно переоценить. Их функции включают:
- В случае угрозы, например, при попадании патогенных микроорганизмов в органы или ткани, зрелые моноциты активно атакуют агрессивных «врагов».
- Они трансформируются в гистиоциты – тканевые макрофаги, которые способны поглощать чуждые клетки, включая бактерии, вирусы и другие болезнетворные агенты, а также продукты их жизнедеятельности. Эти клетки могут справляться даже с патогенами, которые обитают в кислой среде желудка.
- Они отвечают за окончательное разрушение и выведение мертвых болезнетворных клеток.
- После очистки организма от «мусора» макрофаги передают информацию новому поколению моноцитов, что позволяет последним быстро распознавать патогенные (чуждые) клетки и защищать организм от различных патологий.
- Моноциты способны поглощать крупные чуждые агенты, с которыми не могут справиться нейтрофилы, обладающие аналогичными свойствами.
- К дополнительным функциям белых кровяных клеток можно отнести их способность предотвращать образование тромбов в сосудах. Кроме того, они участвуют в процессе кроветворения.
- Они представляют серьезную угрозу для злокачественных клеток, вызывая в них некротические процессы, а также способствуют восстановлению тканей, поврежденных онкологическими или воспалительными процессами.
Важно постоянно контролировать уровень этих компонентов крови. Превышение нормальных значений может свидетельствовать о наличии опасных заболеваний, негативно влияющих на состояние иммунной системы.
Врачи отмечают, что повышение уровня моноцитов у взрослого может свидетельствовать о различных состояниях организма. Это может быть реакцией на инфекцию, воспаление или даже хронические заболевания. Моноциты играют важную роль в иммунной системе, и их увеличение часто указывает на активизацию защитных механизмов. Однако, по мнению специалистов, важно учитывать и другие показатели крови, а также клинические симптомы пациента. В некоторых случаях повышенные моноциты могут быть связаны с более серьезными заболеваниями, такими как лейкемия или аутоиммунные расстройства. Поэтому врачи рекомендуют проводить комплексное обследование для точной диагностики и определения причин изменения уровня моноцитов.
https://youtube.com/watch?v=dGNq459J3hc
Классификация и нормы
Хотя моноциты составляют лишь около 8 % от общего числа белых кровяных клеток, их уровень играет важную роль в диагностике.
При анализе учитывается не только общее количество моноцитов, но и их соотношение с другими типами лейкоцитов, такими как нейтрофилы, базофилы и эозинофилы.
Помимо различия между зрелыми и молодыми моноцитами, рассматриваются еще два ключевых показателя: относительные и абсолютные значения.
Нормальное относительное содержание моноцитов определяется как соотношение этих клеток к другим лейкоцитам. У взрослых это значение стабильно и колеблется от 3 до 11 процентов. Если уровень превышает норму, это состояние называется относительным моноцитозом.
Абсолютное количество моноцитов указывает на их общее число в одном литре крови. Нормальные значения находятся в диапазоне от 0.04 до 0.7 млн/л. Изменения в этих показателях могут указывать на абсолютный моноцитоз.
Отклонения от указанных норм могут свидетельствовать о наличии заболеваний и требуют дополнительного медицинского обследования для выяснения причин.
Важно отметить, что указанные нормы одинаковы для мужчин и женщин.
| Причина повышения моноцитов | Возможные симптомы | Дополнительные исследования |
|---|---|---|
| Инфекционные заболевания (вирусные, бактериальные, паразитарные) | Лихорадка, слабость, боль в горле, кашель, диарея, увеличение лимфатических узлов | Кровь на посев, ПЦР, серологические тесты |
| Воспалительные заболевания (ревматоидный артрит, системная красная волчанка) | Боль в суставах, отеки, кожные высыпания, усталость | Анализ крови на ревматоидный фактор, антитела к ДНК, биопсия |
| Аутоиммунные заболевания | Различные симптомы в зависимости от заболевания | Анализ крови на аутоантитела, биопсия |
| Онкологические заболевания (лейкемия, лимфома) | Увеличение лимфатических узлов, анемия, потеря веса, ночная потливость | Биопсия костного мозга, иммунофенотипирование |
| Послеоперационный период | Боль, воспаление в области операции | Общий анализ крови, контроль за заживлением раны |
| Прием некоторых лекарственных препаратов | Различные побочные эффекты в зависимости от препарата | Анализ крови, консультация врача |
| Стресс | Усталость, раздражительность, бессонница | Психологическое обследование |
Как определяется количество моноцитов
Для определения уровня моноцитов проводится углубленный клинический (общий) анализ крови.
В этом анализе подробно рассматриваются все элементы лейкоцитарной группы.
Для исследования используется венозная или капиллярная кровь. Главное правило подготовки: анализ следует сдавать утром натощак.
Повышение уровня моноцитов у взрослого человека часто вызывает беспокойство и интерес. Многие люди начинают искать информацию о возможных причинах и последствиях этого состояния. В большинстве случаев увеличение моноцитов может свидетельствовать о наличии воспалительного процесса в организме, инфекциях или даже аутоиммунных заболеваниях. Некоторые пациенты делятся своим опытом, отмечая, что после обследования у них были выявлены хронические инфекции или аллергические реакции. Важно понимать, что повышение моноцитов не является диагнозом, а лишь индикатором, требующим дальнейшего изучения. Врачи рекомендуют не паниковать, а обратиться за консультацией, чтобы выяснить причины и получить соответствующее лечение. Многие также подчеркивают важность регулярных медицинских обследований для своевременного выявления возможных проблем со здоровьем.
https://youtube.com/watch?v=GPHJ8zx4x08
Причины нарушений
Концентрация моноцитов в крови считается одним из ключевых показателей здоровья человека и важным маркером для диагностики серьезных заболеваний, которые могут развиваться в организме.
Повышенное содержание моноцитов в крови является особенно тревожным признаком, который в первую очередь может указывать на наличие инфекционных заболеваний. Также стоит учитывать возможность проникновения внутриклеточных паразитов или различных грибков.
Обнаружение увеличенного количества этих белых кровяных клеток может свидетельствовать о наличии различных заболеваний, среди которых наиболее опасными являются:
- Туберкулез, сифилис, бруцеллез, кандидоз и другие системные болезни.
- Тиф, венерические инфекции.
- Заболевания, связанные с нарушениями в системе кроветворения: остеомиелофиброз, лейкоз, полицитемия, хронический миелолейкоз.
- Полиартрит, псориатический и ревматоидный артрит, системная красная волчанка.
- Ревматизм, эндокардит.
- Заболевания органов пищеварения, такие как колит и энтерит.
- Злокачественные опухоли различной локализации, лимфогранулематоз.
- Аутоиммунные заболевания.
Выявление повышенного уровня моноцитов требует более детального обследования и позволяет начать лечение на ранних стадиях заболевания. Это помогает предотвратить развитие состояний, которые могут привести к серьезным последствиям, включая летальный исход.
Другие факторы
Увеличение числа моноцитов может быть связано с ослаблением иммунной системы, что происходит по следующим причинам:
- перенесенные вирусные инфекции, такие как грипп и ОРВИ;
- воспалительные процессы в суставах и сердце, имеющие ревматическую природу;
- состояние пациентов после хирургических вмешательств.
При диагностике важно учитывать все показатели лейкоцитарной формулы. Это позволяет установить степень и стадию заболевания, а также разработать план дальнейшего обследования для выбора наиболее эффективного метода лечения.
https://youtube.com/watch?v=qdS0ch287y0
Когда высокие показатели не считаются опасными
Существуют случаи, когда уровень моноцитов может быть слегка повышен из-за аллергической реакции. Это состояние, как правило, не вызывает серьезных опасений, так как показатели легко возвращаются в норму после устранения аллергена.
Некоторые детские заболевания, такие как скарлатина, ветряная оспа и корь, также могут проявляться умеренным увеличением количества моноцитов. Это происходит, когда организм активирует свои защитные механизмы для борьбы с инфекцией.
Кроме того, рост уровня моноцитов в процессе выздоровления может указывать на положительные изменения в состоянии здоровья.
Причины повышения у женщин
Важно подчеркнуть, что специфические характеристики женской физиологии могут способствовать увеличению уровня моноцитов.
Во время беременности наблюдаются отклонения от нормальных показателей, что может быть вызвано проникновением различных инфекций, таких как ОРВИ, герпес или грипп.
Кроме того, моноцитоз часто проявляется в первом триместре. Это связано с увеличением общего числа лейкоцитов и необходимостью усиления защитных функций организма в период вынашивания ребенка.
Также стоит отметить, что прерывание беременности с помощью аборта может привести к повышению уровня белых кровяных клеток.
Методы нормализации значений
Следует отметить, что специфические симптомы, указывающие на увеличение уровня моноцитов, отсутствуют.
Тем не менее, если вы замечаете у себя склонность к различным недомоганиям и медленное восстановление после даже незначительных заболеваний, это может стать поводом для проведения клинического анализа крови.
Обнаружение отклонений от нормальных показателей служит основанием для дальнейшего обследования, которое поможет выявить заболевание, ставшее причиной повышения уровня лейкоцитов.
Не существует универсальных методов лечения моноцитоза, поскольку это состояние не является самостоятельным заболеванием, а лишь симптомом, указывающим на наличие патологии. Поэтому основное внимание уделяется лечению заболевания, вызвавшего увеличение моноцитов.
Если повышение уровня моноцитов связано с реакцией организма на грибковую инфекцию, лечение будет сосредоточено на ее устранении. В таких случаях показатели крови восстанавливаются достаточно быстро.
Однако при наличии более серьезных заболеваний, таких как лейкоз или онкология, процесс снижения уровня моноцитов может быть более сложным и длительным. В этом случае выбор стратегии лечения будет направлен на борьбу с тяжелым недугом.
Важность нормальных показателей
Раннее обнаружение отклонений от нормы позволяет предпринять необходимые действия, провести дополнительную диагностику и предотвратить развитие серьезных заболеваний, которые могут угрожать здоровью или жизни пациента.
Важно осознавать, что самостоятельно нормализовать показатели, даже при небольших отклонениях, невозможно.
Только своевременное обращение к врачам и строгое соблюдение их рекомендаций помогут избежать нежелательных последствий.
Таким образом, ключевым принципом в борьбе с любыми заболеваниями следует считать регулярное прохождение профилактических осмотров, которые включают лабораторные и инструментальные методы диагностики.
Вопрос-ответ
Почему повышены моноциты у взрослого?
Повышенные моноциты в крови часто являются результатом инфекционных заболеваний, таких как мононуклеоз или аутоиммунное заболевание. Но моноцитоз может развиться даже по менее серьезным причинам, таким как хронический стресс или высокая физическая активность.
Что означает переизбыток моноцитов?
Моноцитоз — увеличение числа моноцитов в крови. Может наблюдаться при острых и хронических воспалительных процессах, при которых моноциты направляются в очаги воспаления и дифференцируются в тканевые макрофаги.
Какой вид рака связан с высоким уровнем моноцитов?
ХММЛ — это тип рака крови. При ХММЛ организм вырабатывает слишком много моноцитов (типа лейкоцитов). Также может вырабатываться недостаточно некоторых других типов клеток крови. Если в крови слишком много моноцитов, они могут оседать в селезенке или печени, увеличивая эти органы в размерах.
При каких вирусах повышаются моноциты?
Повышение уровня моноцитов может наблюдаться при инфекциях, вызванных вирусами, такими как вирус Эпштейна-Барр (EBV), цитомегаловирус (CMV), вирус гриппа, а также при некоторых других вирусных инфекциях, включая ВИЧ и вирусы гепатита. Эти вирусы могут вызывать реакцию иммунной системы, приводящую к увеличению количества моноцитов в крови.
Советы
СОВЕТ №1
Обратите внимание на свое питание. Включите в рацион продукты, богатые витаминами и минералами, особенно витамином C, фолиевой кислотой и цинком. Это поможет поддерживать иммунную систему и может способствовать повышению уровня моноцитов.
СОВЕТ №2
Регулярно занимайтесь физической активностью. Умеренные физические нагрузки, такие как прогулки, йога или плавание, могут улучшить общее состояние здоровья и способствовать нормализации уровня моноцитов в крови.
СОВЕТ №3
Управляйте стрессом. Хронический стресс может негативно влиять на иммунную систему. Практикуйте методы релаксации, такие как медитация, глубокое дыхание или занятия хобби, чтобы снизить уровень стресса и поддерживать здоровье.
СОВЕТ №4
Регулярно проходите медицинские обследования. Консультация с врачом и регулярные анализы крови помогут отслеживать уровень моноцитов и выявлять возможные проблемы на ранней стадии. Не игнорируйте рекомендации специалистов.